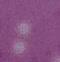

PÁGINA 18 PÁGINA 04
Netlflix confirma presença nos Notáveis USA 6,7,12 & 14 ANO 16 • EDIÇÃO 55 • JULHO/AGOSTO 2023 Speedmax Signs, a sua parceira em propaganda visual nos Estados Unidos A brasileira Shirley Maia Cusick é candidata ao Senado dos EUA por New Jersey
PERSONALIDADE DO ANO DE 2022 LEIA MAIS NAS PÁGINA 16 & 17 Celebra a Cultura Brasileira nos EUA
Ator que é sucesso na
Georgeana Frias inaugura nova clínica de estética
Na ensolarada Flórida, o advogado
Danilo Brack, especializado em imigração, se destaca como um guia para aqueles que buscam novas oportunidades em terras estrangeiras. Com uma paixão pela justiça e uma compreensão abrangente das complexidades do sistema de imigração, ele oferece seus serviços para ajudar indivíduos e famílias a navegarem nos desafios e nas esperanças de uma vida em um novo país.


Desde jovem, Danilo sempre teve uma sensibilidade para as lutas e aspirações das pessoas ao redor do mundo. Sua própria história de descendência imigrante o inspirou a seguir a carreira jurídica, com o objetivo de fazer a diferença na vida dos imigrantes. Após anos de dedicação aos estudos e à prática jurídica, se tornou um especialista respeitado no campo da imigração.
Situado em um escritório acolhedor em Orlando, Danilo Brack trabalha incansavelmente para entender as necessidades únicas de cada cliente que procura seus serviços. Ele sabe que cada caso é único e requer uma abordagem personalizada. Ao oferecer orientação legal individualizada, ele alivia o estresse associado ao processo de imigração e transmite confiança a seus clientes.



Seja para reunir fa-
mílias, buscar oportunidades de trabalho ou escapar de situações difíceis em seus países de origem, Danilo Brack entende a importância do sucesso no processo de imigração. Ele lida com uma ampla gama de casos, desde vistos de trabalho e estudo até as complexidades da obtenção da cidadania ame-

ricana. Sua experiência e conhecimento jurídico permitem que ele navegue pelos intricados trâmites legais com eficiência e habilidade.
























Além de seu compromisso com a excelência profissional, John Silva é conhecido por sua compaixão e empatia para com seus clientes. Ele se esforça para ouvir atentamente suas histórias e compreender suas esperanças e temores. Sua abordagem centrada no cliente cria um ambiente onde todos se sentem valorizados e apoiados durante a jornada de imigração.

a tomarem decisões informadas sobre seus futuros nos Estados Unidos. Sua vontade de compartilhar conhecimento e recursos gratuitos demonstra seu compromisso com o bem-estar da comunidade em geral.




































Com a dedicação e habilidades e Brack, muitos imigrantes encontraram uma luz guia em suas jornadas rumo a uma vida melhor na Flórida e nos Estados Unidos. Ele continua a ajudar pessoas de todas as origens a alcançarem seus sonhos e a construírem um futuro promissor em solo americano.
Danilo Brack é uma figura inspiradora que representa não

apenas a expertise jurídica, mas também a compaixão e o apoio emocional necessários para enfrentar os desafios da imigração. Com ele ao lado, seus clientes têm a certeza de que não estão apenas contratando um advogado, mas também um amigo confiável e um defensor incansável em sua busca por novas oportunidades na Flórida e além.










um ambiente inclusivo em seu












Danilo Brack também valoriza a diversidade cultural e promove um ambiente inclusivo em seu escritório. Como ele fala português, possibilita uma comunicação mais fácil com clientes brasileiros, que entendem facilmente o processo.
Além de seus gração, Brack dedica parte de inforTube. Ele acredi-











pacitar os imigrantes
Além de seus serviços individuais de imigração, Brack dedica parte de seu tempo para oferecer informações importantes através de suas redes sociais e o seu canal no You Tube. Ele acredita que a educação é fundamental para capacitar os imigrantes

ADVERTISING
02 da Redação da BT Magazine REPRESENTAÇÃO
diferenciado para
a legalização nos EUA MAIN OFFICE 648 Central Street, 2nd Fl, Lowell, MA. Telefone: (978) 453-7225 BOSTON AREA OFFICE: 12 Irving Street, Suite 203, Framingham, MA. FLORIDA OFFICE: 618 E South Street, Suite 500, Orlando, FL RIO DE JANEIRO OFFICE: Rua Debret, 79, Suíte 709, Centro, RJ ...você em boas mãos sempre! Dra Bernadete Campos - Formada no Brasil e EUA Marque já a sua consulta! • Implantes dentários • Tratamento de canal • Tratamento de gengiva • Lentes de contato em resina e porcelana Botox & preenchimento 777 Concord Ave- Suite 303 Cambridge- MA - 02138 (617) 498-0777 Oferecemos planos de pagamento próprio e facilitamos pagamento
Advogado de Imigração na Flórida BrackLaw oferece atendimento
quem busca
QUEM CUIDA DE PARENTES DOENTES EM CASA, PODE RECEBER POR ISSO
A brasileira
Lorena Silva-Herman, é natural de Goiânia, vive nos Estados Unidos há 30 anos. Uma profissional altamente qualificada, é bacharel em enfermagem, mestre em administração e enfermagem e doutora em enfermagem. Gestora executiva há mais de 20 anos na área da saúde e há seis meses assumiu a presidência da Vitra Health.



A Vitra Health é uma clínica dedicada a fornecer apoio a indivíduos e famílias para que eles possam cuidar de seus ente queridos, no conforto da sua casa com assistência financeira e o apoio de uma equipe bem capacitada, composta por enfermeiras e assistentes sociais: “Nossa missão foca em manter famílias e nossas comunidades unidas com o apoio de que precisam e remunerar um membro da família para que cuidem do seu ente querido (a). Nossa equipe de enfermeiros e assistentes sociais tornam-se parte das famílias e comunidades que servimos dando assistência clínica e social”.
Os serviços da Vitra Health são focados em ajudar comunidades e famílias para que elas possam escolher parentes para cuidá-los com o apoio das enfermeiras e assistentes sociais. Os nomes dos programas são: Adult Family Care (AFC), que fornece apoio financeiro e clínico a clientes (famílias e cuidadores). O serviço é oferecido em todas as cidades no Estado de Massachusetts.
“Temos orgulho de ter uma equipe de funcionários que reflete as comunidades que servimos. Com 67% de nossos funcionários sendo membros da População de Maioria Global (PGM) / negros, indígenas, pessoas de cor (BIPOC) e fluentes em vários idiomas; nós abraçamos o poder da comunidade e diversidade cultural. Nossa equipe vive nas comunidades que servimos e entendem a importância da família na saúde e bem-estar das comunidades. Ao promover uma equipe que entende e aprecia e se identifica com os nossos clientes, podemos nos conectar melhor e apoiar famílias de todas as culturas e países”.
nectar melhor e apoiar famílias de serviços da Vitra Health permitem
nossos serviços. Estes incluem MassHealth Standard, MassHealth CommonHealth, Accountable Care Organizations, One Care (Commonwealth Care Alliance, Tufts Unify), PACE (East Boston Neighborhood Health Center, Harbor Health) e Senior Care Options (Boston Medical Center, Commonwealth Care Alliance, Fallon, Senior Whole Health, Tufts, United Healthcare). Nosso objetivo é acomodar o maior número possível de pessoas e tornar nosso suporte amplamente disponível”.
É importante ressaltar que existe apoio financeiro e clínico disponível para os cuidadores e suas famílias, e que o serviço é oferecido em todo o estado de Massachusetts.

“Nosso objetivo é apoiar famílias a continuar a viver em suas comunidades e casas com a ajuda de seus entes queridos. Vitra ajuda os cuidadores a obterem recursos e assistência permitindo-lhes serem remunerados enquanto mantêm as famílias unidas, e recebendo também apoio clínico e social”.
Perguntamos à Lorena sobre o diferencial dessa instituição e ela afirma que o maior diferencial é a diversidade dos profissionais, uma equipe composta por quase setenta por cento de imigrantes e filhos de imigrantes, isso compõe uma equipe multicultural, falante de diversos idiomas, inclusive o português. Esse perfil dos funcionários aproxima os clientes.
Sobre os valores da ajuda de custo para o cuidador, ela recomenda aos interessados a entrarem em contato com a equipe. O telefone dos representantes brasileiros se encontra no final da matéria.








Para os cuidadores é essencial saber que eles não estão sozinhos, e há ajuda ao seu alcance. Entre em contato com a equipe e tire as suas dúvidas.
Contatos



munerados, ou seja, é a famí-
O comprometimento com a inclusão está no centro do trabalho, permitindo ajudar as famílias a permanecerem juntas e prosperarem. É importante também ressaltar que os serviços da Vitra Health permitem que as famílias escolham seus entes queridos para ajudá-los e serem remunerados, ou seja, é a família que escolhe o cuidador”.
Kelly Fernandez Telefone
413-412-9411
Andreia Freitas Telefone

508-208-9233



































































profissionais ajudam no processo


















A companhia atua em parceria com vários seguros de saúde. Os profissionais ajudam no processo burocrático para a pessoa aplicar e certificar se é elegível para o pro-
“Aceitamos vários planos de saúde para garantir acessibilidade aos
www.instagram.com/vitrahealth
www.facebook.com/vitrahealth

www.linkedin.com/company/vitrahealth/









03 da Redação da BT Magazine VITRA HEALTH
Lorena Silva-Herman é a presidente da Vitra Health e está reunindo esforços para expandir os serviços à comunidade brasileira
tado de Massachusetts.
grama.
Texto de Eliana Marcolino
Brasileira é candidata ao Senado dos EUA por New Jersey
Shirley Maia Cusick é uma brasileira que vai concorrer ao Senado Federal pelo estado de New Jersey. É a primeira brasileira a encarar um desafio desta altura. Ela é uma empresária de sucesso no setor de consultoria e advocacia imigratória e fala fluentemente três idiomas.
Há muitos anos se dedica ao seu Escritório Worldwide Legal Services em Short Hills, no atendimento de empresários que investem nos Estados Unidos, assim como também na legalização de imigrantes que se qualificam dentro da lei imigratória.
Como cidadã norte-americana, ela decidiu que precisava se posicionar politicamente para conseguir fazer diferença no futuro de seus netos pois percebeu o quanto a educação está se deteriorando nas escolas públicas onde se prioriza as agendas progressistas ao invés da base principal da educação.
Shirley percebeu que poderia fazer diferença no país se candidatando ao Senado Federal, onde se aprova as Federais como por exemplo na área migratória.
Crescendo em Brasília, sempre esteve cercada por turistas americanos e diplomatas. Foi assim que se interessou em aprender inglês. Shirley decidiu imigrar para América no início dos anos 90 permanentemente de maneira legal e logo se tornou cidadã deste país. Mãe de três filhas e a procura de estabilidade econômica e de viver o sonho americano.
Construiu seu negócio de sucesso no ramo da advocacia migratória enquanto fazia o melhor e mais difícil trabalho do mundo: Criar suas filhas.
Sua decisão final para ingressar na política veio de seu primeiro neto que decidiu ingressar para servir na Tropa de Elite da Marinha Americana. Com uma avó dedicada tentou levar seu neto para opções menos arriscadas, mas a persistência e força de seu neto em dizer que queria se sacrificar pela sua nação mudou o coração de Shirley levando a se envolvendo mais no governo local apoiando alguns candidatos, mas ainda não era suficiente foi quando a fez perceber que tinha o dever cívico de fazer mais.









Shirley é uma candidata conservadora, com valores baseados na família e nos princípios cristãos e
está concorrendo pelo partido Republicano como Senadora Federal
Ela diz: “Estou correndo para capacitar os pais, pois não estou bem com esse sistema educacional e estou correndo para elevar a educação neste país.
Sobre política externa ela é contra comprometer recursos dos impostos do cidadão para enviar a conflitos estrangeiros apoiando guerras antes de cuidar dos próprios cidadãos Americanos.
Sobre imigração ela é contra a abertura da fronteira dando direitos a pessoas que nem têm como checar seus antecedentes criminais enquanto imigrantes bons cidadãos que colaboram com impostos a décadas estão esquecidos pelo sistema.
Ela diz que fechar a fronteira não significa ser contra famílias que sonham em oportunidades, mas significa que precisamos parar o tráfico infantil (85 mil crianças desacompanhadas sumiram do sistema no governo Biden e ninguém sabe o paradeiro delas.
E isso é apenas as crianças que entraram no sistema fora as que não foram cadastradas, recebidas pelo ICE e nem fazem parte dos números).


A candidata também luta para maior controle da fronteira pelo tráfico de drogas descontrolados. Enfim, ela resume em fechar as portas e consertar o interior da casa primeiro priorizando os seus moradores para depois pensar em políticas de recebimento de novos imigrantes.
Shirley diz: “Estou concorrendo para colocar as necessidades da América em primeiro lugar. Já se passaram 44 anos desde que um republicano representou Nova Jersey no Senado Federal, é hora de uma nova liderança.”


O concorrente de Shirley e atual Senador democrata Bob Menendez (Há 17 anos Senador federal pelo estado de New Jersey).
Alguns especialistas e comentários dos bastidores políticos dizem que ela é a favorita nas primárias republicanas de New Jersey, e que será a única que vai aposentar o Democrata Menendez. Para ela ganhar esta batalha e lutar por todos nós ela precisa de muitos voluntários para divulgá -la na mídia e também doações financeiras da qual poderá ser feita direto no Website que dela é controlado pelo governo.
Acompanhe o trabalho de Shirley Maia Cusick:
THE BEST MAGAZINE FOR YOU
Founded in August / 1988


(617) 625-5559
1-877-625-0079
www.braziliantimes.com

E-mail: (opinião/opinion) news@braziliantimes.com (anúncio/marketing) ad@braziliantimes.com


EDIRSON PAIVA Publisher
STAFF NEWS

EDIRSON PAIVA JR. Chief Editor
CRISTINA PAIVA Finance Director
LUCIANO SODRÉ Assistant Editor
CORRESPONDENTS IN BRAZIL
Claudia Carmo
São Paulo, SP
Albertina Moura
Belo Horizonte, MG
COLUMNISTS
Arilda Costa (New York)
Marisa Abel (NewYork)
Gisele Cadamuro (Mt. Vernon, NY)
Claudia Cascardo (Newark, NJ)
Lucy Rodrigues (South Carolina)
Marcia Davidowski (Arizona)

Claudia Ramalho (Philadelphia)
Bibi (Newark, NJ)
Francisca Benvenuto (NY)
Patricia Peixoto (Chicago, IL)
JOURNALIST
Camila Oliveira
Selma Kamim (São Paulo - BR)
MARKETING DEPARTMENT
Liliane Paiva
Daniele Deghi
Patty Peixoto
Jane Bencke
GRAPHIC DESIGNER


Everson Menezes
DIRECTOR OF PHOTOGRAPHY
Paulo Lopes

EVENTS COORDINATOR








Daniele Deghi & Liliane Paiva
CIRCULATION DEPARTMENT
Christiane Paiva
Valéria Guinancio
José Joaquim Guimarães
MAILING ADDRESS



Brazilian Times
P.O.Box 447 Somerville, MA 02143
Os artigos assinados e/ou colunas e cartas, são de responsabilidades de se- autores e não refletem, necessariamente, a opinião deste jornal. O Brazilian Times não é responsável pelo conteúdo dos mesmos. Signed articles, columns and letters do not necessarily reflect the views of the newspaper or its publishier. The Brazilian Times accepts no responsibility for their content.
da Redação da BT Magazine POLÍTICA

Celebrando a Cultura Brasileira nos Estados Unidos
No Estados Unidos, um evento único e emocionante aconteceu para homenagear a rica cultura e as contribuições dos brasileiros que escolheram chamar esse país de lar. O Notable Brazilian Award, mais conhecido como “Notáveis USA”, é um verdadeiro encontro de culturas, que estreita laços entre e promove o respeito mútuo e a diversidade. posição conta a história dos

O evento, idealizado pela Brazilian Community Heritage Foundation, é realizado em New York sempre com o objetivo de refletir a importância de compartilhar as tradições brasileiras com a comunidade local e internacional.
A cerimônia reúne brasileiros de várias regiões dos Estados Unidos, de diferentes origens e profissões, cada um trazendo consigo a sua história de superação, conquistas

e contribuições para a sociedade. Do acadêmico ao empreendedor, do artista ao chef de cozinha, todos têm algo em comum: o amor e orgulho pela cultura brasileira.

A cerimônia de entrega das homenagens é repleta de cores vibrantes e apresentações artísticas que capturavam a essência da cultura brasileira. Uma exposição conta a história dos homenageados e paralelo a isso, acontece uma exposição de artistas plásticos que destaca o talento de alguns brasileiros.

exemplos inspiradores, fica evidente o papel crucial dos brasileiros na construção e fortalecimento da sociedade norte-americana.
O prêmio foi criado em 2011 e é organizado pela Brazilian Community Heritage Foundation (BCHF). A cerimônia de premiação acontece anualmente em New York e conta com a presença de autoridades, líderes empresariais, religiosos, artistas e outras personalidades.
Os premiados são escolhidos por meio de um processo de indicação e posteriormente votação. Em ambos, a comunidade tem uma participação importante.
de um processo de indicação e posteriorde tem uma participação importante.
menagens a aos que se destacaram em

Durante o evento, são prestadas homenagens a aos que se destacaram em suas áreas de atuação nos Estados Unidos, no Brasil e em outros países. Personalidades que alcançaram posições de destaque em empresas, instituições de ensino e organizações não-governamentais são reconhecidos por seu trabalho árduo e dedicação. Através desses

O evento deste ano vai acontecer no dia 02 de setembro, no NYC Event Center, localizado no 4W 43rd Street, Manhattan (NY).

Para reservar um convite ou obter mais informações, ligue no telefone 1-877-


























































































625-0079.

O evento deste ano vai acontecer no em lho árduo e dedicação. Através desses





O EMPODERAMENTO DA MULHER BRASILEIRA É DESTAQUE NO EVENTO






da Redação da BT Magazine NOTÁVEIS 2023
APRESENTAÇÃO



























































PARTICIPAÇÃO ESPECIAL
















































































MÚSICA





















































































REALIZAÇÃO CO-REALIZAÇÃO EXPOSIÇÃO DE ARTE PRODUÇÃO
Sergio Buq Cantor
Raysa Shesuê apresentadora
Programa Brazilian Times entrevista Fernando Liberal, o pioneiro em Magnetismo no Brasil


OBrazilian Times desta semana trouxe Fernando Liberal para um bate papo exclusivo. Considerado o pioneiro em Magnetismo no nosso país, Liberal afirma que todos nós possuímos esse magnetismo dentro de nós, sem termos acesso, por falta de conhecimento.
Nascido no Rio de Janeiro, 40 anos, formado em administração, é considerado especialista e mestre da mente humana para o desenvolvimento pessoal. Tem transformado vidas de milhares de pessoas através das suas técnicas e conhecimento. Ainda, foi o primeiro profissional a trazer as técnicas milenares da Fascinação e Magnetismo ao Brasil que são poderosas ferramentas utilizadas desde a época do Antigo Egito. Nelas, o não verbal é a maior ferramenta para falar diretamente com a mente primária, ou seja, a nossa mente mais profunda. É possível desenvolver a verdadeira Presença Magnética e descobrir as chaves escondidas do Olhar, mudando positivamente a sua realidade e de outras pessoas, também. Utiliza símbolos mesméricos em conjunto com o Magnetismo Animal, onde é possível tratar doenças físicas e mentais.


“Eu cresci na comunidade do Rio de Janeiro, em meio a tiros e guerras diárias, minha
fortaleza sempre foi minha mãe, que criou a mim e a meu irmão sozinha, no meio desse caos. Eu sabia que ali não era o meu lugar e que aquela realidade era passageira. Com 14 anos, trabalhei vendendo yakult de porta em porta com carrinho de feira em todas as comunidades e morros próximos. Passei muita necessidade, minha mãe teve depressão, mas batalhei muito para melhorar a nossa realidade. Eu sabia que o mundo tinha coisas melhores, mas eu precisava mostrar ao mundo quem eu era”, completa Liberal.
quais poucos têm acesso ou conhecem. Em outras palavras, poder ajudar as pessoas a melhorarem suas vidas tanto no âmbito emocional, energético, espiritual e material. Liberal afirma que a evolução financeira é consequência de uma vida plena que pode ser conseguida através desse conhecimento.

O programa BRAZILIAN TIMES ENTREVISTA

A saber, Liberal decidiu fazer lives semanais (todas às quintas-feiras às 21 horas) através de seu instagram @ fernandoliberaloficial onde procura esclarecer questões a respeito da espiritualidade, pois afirma que seu objetivo é mostrar os conhecimentos secretos e ocultos dos



acontece todas às quartasfeiras a partir das 20 horas (horário de Brasília) e às 19 horas (Horário de NYC) com Denny Silva e Uiara Zagolin. É transmitido a mais de 220 países através de sete canais de TV via streaming e ainda simultaneamente pela Rádio Brazilian Times. Então, assistam a entrevista pelo canal do Brazilian Times no Facebook e pelo YouTube.


https://www.youtube.com/live/ pD9wSr1TmjE?feature=share


08 da Redação da BT Magazine BRAZILIAN TIMES ENTREVISTA
Thiago Moraes é destaque no programa Brazilian Times



Entrevista
OBrazilian Times
Entrevista desta semana recebeu o professor e jurista, Thiago de Moraes, para um bate papo sobre direitos humanos e também sobre o lançamento do seu livro “A Evolução Econômica Social”.
Thiago é Professor, escritor membro da União Brasileira dos Escritores e CBL, colunista da Carta Forense, bacharel em Direito pela USP – Largo São Francisco (2010), bacharel em Ciência da Computação e licenciado em Matemática Aplicada pela PUC SP (2003). Igualmente, é membro pesquisador do
IBCCRIM, membro honorável do associações de defesa dos direitos difusos e coletivos, presidente e fundador do Instituto Assistencial Justiça Solidária, Reitor no Instituto de Educação São Paulo.
Também é mestre em Filosofia do Direito pela USP (2012) e doutor pela UNB (2015),especializado em Direitos Humanos pela FGV (2016), certificado em Retórica e Oratória pelo Instituto de Oratória Reinaldo Polito (2012) e Teatro Executivo pela FAAP (2012). Proficiente em Inglês, Espanhol, Hebraico,La-
tim e Francês. Foi Presidente do Centro Acadêmico da Faculdade de Ciências Exatas da PUC – CACEX Abraão de Moraes por dois anos e começou a trabalhar em diversas academias, através de ensaios sobre problemas sociais e econômicos. Estagiou na própria instituição, no Juizado Especial e no Escritório Modelo Dom Evaristo Arns.
Idealizador e mentor do projeto de debates sobre Gestão Pública, Reestruturando o Município de São Paulo; Doar é Legal: A Vida é Recarregável


(iniciativa à doação de órgãos) e responsável pelas exposições Legado de Leonardo Da Vinci (2013). Ainda, o Fim de Jogo no Fórum João Mendes; Juntos contra a Prostituição Infantil, Memórias da Rua e Infância em Risco. Infância em riscocombate do trabalho escravo infantil. Também, autor no Teatro Macunaíma e FAAP do Monólogo - O estatutos do Homens; O auto da barca do inferno - Gil Vicente ; Danton: O processo da revolução; Monólogo - Auto retrato; A hora da estrela - Clarice Linspector; Suburbano coração - Naum Alves de Souza; Ensina-me a viver - Colin e Hamlet - Shakespeare.
Os seus projetos atuais envolvem a Fundação e Instituto Assistencial Justiça Solidária; palestras -*Como citar em biografia;*Tráfico internacional de pessoas;*Doar é legal - doação de órgãos - a vida é recarregável*Gestão Pública - Reestruturando o município de São Paulo - Mentor e idealizador . Autorizado pela Presidente Curadora Celita Procópio de Carvalho


09 da Redação da BT Magazine BRAZILIAN TIMES ENTREVISTA
BT lança loja online com ampla variedade de produtos a preços competitivos
Pensando em ampliar o seu leque de atendimento, o grupo Brazilian Times lançou uma loja online com uma variedade de produtos a preços competitivos. Desde roupas e acessórios até eletrônicos e produtos de beleza, o site tem tudo o que os compradores procuram para tornar suas vidas mais fáceis e divertidas.

A equipe responsável pelo site trabalhou duro para criar uma experiência de compra online fácil de usar e navegável. Com um processo de pagamento seguro, os compradores podem ter certeza de que suas informações pessoais e financeiras estão protegidas em todos os momentos.

Para comemorar o lançamento, a loja está oferecendo descontos em vários produtos. Os compradores que visitarem o site poderão aproveitar

























essa oportunidade para comprar seus produtos favori-



essa oportunidade para comprar seus produtos favoritos a preços incríveis.













Para conhecer mais sobre a loja, chamada BTimeShop, acesse o site Para mais informações, visite o site www.btimeshop.com











10 da Redação da BT Magazine COMPRAS ONLINE

As atrações confirmadas do evento Notáveis deste ano















































HOMENAGEANDO OS BRASILEIROS DE DESTAQUE QUE VIVEM NOS EUA E AO REDOR DO MUNDO
nos
































No evento deste ano estão confirmadas as cantoras Joanna Nova York, Farah Crespo, o saxofonista Gilton Martinez. Como apresentação principal foi convidado o cantor Sérgio Buq, que tem uma grande ligação e história com a música popular brasileira.






A apresentação estará sob o comando de Amadeu Maya (Mestre de Cerimônia), George Roberts (Apresentador), Marisa Abel e Rayssa
Shesue (Apresentadoras).











Também haverá uma apresentação de arte sob a coordenação da InArt Café.
o dia 2 de setembro vai acontecer em Manhattan, New York, o XIII Notable Brazilian Awards, conhecido como “Notáveis USA”, o evento que homenageia brasileiros Estados Unidos e em outros países. Entre os homenageados estarão jornalistas, empresários, artistas, profissionais liberais, líderes políticos e religiosos, personalidades entre outros. e













O Notáveis USA é uma produção da Classic Produção, Realização da Brazilian Community Heritage Foundation, co-realização do Museu do Imigrante Brasileiro




da Redação da BT Magazine NOTÁVEIS 2023
12
Grand Construtora anuncia novo empreendimento no Espírito Santo e oferece atendimento especial aos brasileiros nos EUA
AGrand Construtora, renomada empresa do ramo da construção civil no Espírito Santo é a construtora brasileira que mais vende imóveis nos Estados Unidos. Os seus diretores revelaram planos incríveis para um novo empreendimento, que promete transformar o cenário imobiliário no estado capixaba.
Batizado de “Taj Home Resort”, o projeto promete trazer inovação, luxo e sustentabilidade para a região, tornandose um marco arquitetônico na cidade e um dos maiores do Brasil.
Localizado em uma área estratégica, de frente para o mar, na cidade de Vila Velha, no bairro Jockey de Itaparica, se
destaca pela sua modernidade e elegância. Com uma proposta arrojada, num terreno de 30 mil metros quadrados, o empreendimento contará duas torres residenciais, uma com 25 e outra de 50 andares, sendo edifício mais alto do Espírito Santo.
Ele possui apartamentos privativos, sendo um de 280m², com 4 suítes, 4 vagas de gara-
gem, e outro de 160 m², com 3 suítes e 3 vagas de garagem, 21 mil metros de área de lazer.

É um resort com piscinas aquecidas, quadra de futebol, tênis, academia, salão de festas, espaços verdes e serviços diversos, além de uma área comercial integrada, oferecendo espaços para escritórios e lojas de alto padrão e com muita segurança.
A Grand Construtora tem um histórico sólido e consolidado no mercado, sendo conhecida por seus projetos de qualidade e excelência, que há 10 anos vem conquistando clientes brasileiros que moram nos Estados Unidos. Isso porque ela oferece um atendimento exclusivo e sabe da necessidade e conhece o perfil das pessoas que querem adquirir um imóvel no Brasil.

Com o Taj, a empresa busca elevar ainda mais o patamar de sofisticação, entregando aos clientes um estilo de vida diferenciado.


A Grand Construtora tem um forte compromisso com a sustentabilidade e o Taj não é exceção. O empreendimento contará com sistemas de captação de energia solar, reutilização de água e materiais de construção sustentáveis, com o objetivo de reduzir o impacto ambiental e promover a preservação dos recursos naturais.


O lançamento do Taj está pre-
visto para 2026 e a expectativa é que o empreendimento seja um sucesso, atraindo investidores, compradores e contribuindo para o desenvolvimento econômico da região.
A Grand Construtora tem se destacado ao longo dos anos por sua capacidade de entregar empreendimentos de alta qualidade e se tornou referência no mercado imobiliário.

Com o Taj, a Grand Construtora reforça seu compromisso em proporcionar projetos inovadores e de alto padrão, que aliam conforto, design arrojado e sustentabilidade.






O novo empreendimento promete deixar sua marca no Espírito Santo, redefinindo o conceito de moradia e estabelecendo novos padrões para o setor imobiliário local.

Para conhecer e obter mais informações sobre o Taj, um dos maiores empreendimentos do Brasil, acesse o site https://grandconstrutora.com.br/imovel/taj-home-resort/


13 da Redação da BT Magazine INVESTIMENTO
Texto de Claudia Carmo
HOMENAGEANDO OS BRASILEIROS DE DESTAQUE QUE VIVEM NOS EUA E AO REDOR DO MUNDO
Ator que é sucesso na Netlflix confirma presença no NOTÁVEIS USA





































Oator e comediante Edmilson Filho é uma das personalidades confirmadas para participar do Notable Brazilian Awards deste ano. O evento, mais conhecido como Notáveis USA, é realizado para homenagear os brasileiros que se destacaram em suas áreas de atuação nos Estados Unidos e em outros países, inclusive no Brasil.


Na semana passada, o produtor Marcello Malcher, da Aquarela Produções, conversou com ele e durante a entrevista, o astro de vários filmes e sucesso na Netflix falou da carreira, vida familiar e Estados Unidos.

Edmilson é o terceiro filho de uma família de quatro, sendo o único homem com três irmãs. Ele iniciou a sua vida nas artes marciais quando tinha apenas 12 anos de idade, sendo praticante do Kung Fu. Pouco tempo depois começou a praticar Taekwondo. Isso o levou a conhecer mais de 15 países, disputando competições e participando de intercâmbios e seminários.
Antes de entrar para o mundo do cinema, Edmilson começou como comediante de stand-up, aos 17 anos de idade, em sua cidade natal, Fortaleza (Ceará). Ainda na adolescência, ele participou do primeiro curta-metragem chamado de “O Artista contra o Caba do Mal”, que no futuro foi adaptado para o longa-metragem “Cine Holliúdy”.


Foi este longa que lhe abriu as portas do sucesso e rendeu vários prêmios, inclusive o “Prêmio Quem 2013” de melhor ator.





















Durante o tempo em que morou nos Estados Unidos, Edmilson teve de perto a percepção das diferenças culturais entre brasileiros e norte-americanos e com isso teve a ideia de fazer uma peça juntamente com Halder Gomes, a Made In Ceará, que realiza desde 2013 e atualmente novo espetáculo Notas – Uma Comédia de Relacionamentos. Em 2015, atuou no primeiro episódio da série Os Experientes como um segurança atrapalhado e paralelamente protagonizou as três temporadas da websérie Tome Prumo.
Em 2018, retornou ao papel de Francis nos cinemas com a sequência de Cine Holliúdy 2: A Chibata Sideral e na TV, estrelando ao lado de Letícia Colin, Cine Holliúdy, agora como série, exibida pela Rede Globo.



Durante a conversa com Malcher, Edmilson falou sobre sua vida e envolvimento com os Estados Unidos, que começou em 1999, quando o Brasil não se classificou para as Olimpíadas na modalidade de Taekwondo. Ele decidiu passar um período de seis meses na Califórnia, onde morou na casa do professor de uma academia em Los Angeles. “Vendi tudo o que tinha no Brasil, paguei as contas e vi para treinar e aprende inglês”, disse ele ressaltando que já se passaram 23 anos.
Cartaz Cine Holliúdy



Foi nos Estados Unidos que ele conheceu a sua esposa, Melissa, uma cidadã norte-americana, com quem tem duas filhas, Chloe e Madeleine. Durante este período ele continuou envolvido com as artes marciais e participou de várias competições e em 2004, se mudou para a Inglaterra com a esposa, onde sua filha mais velha nasceu, na cidade de Londres.
Mas pouco tempo depois, após a Inglaterra ser alvo de ataques terroristas eles voltaram para o Brasil e decido à empresa que sua esposa trabalhava, foi morar em Nevada, onde abriu uma academia de Taekwondo, e depois se mudaram para Phoenix, no Arizona, onde ele também abriu uma academia.
da, onde abriu uma academia de mudaram para Phoenix, no Arizona, onde ele


Em 2012 a família retornou para a Califórnia envolvido com o mundo das artes marciais e cine“O

se. “Depois disso, vários projetos foram

Em 2012 a família retornou para a Califórnia e durante todo este período ele se manteve envolvido com o mundo das artes marciais e cinema. “O longa que me lançou, o Cine Holliúdy, demorou oito anos para ficar pronto”, disse. “Depois disso, vários projetos foram criados tudo envolvendo o nordeste brasileiro”, continuou.
Atualmente, Edmilson tem filmes sendo transmitidos pela Amazona, Globo Play, Netflix e tem um projeto que será lançado pela Disney em outubro.
da Redação da BT Magazine NOTÁVEIS 2023
Cartaz Cabras da Peste
Com sua família









BRACKLAW AGENDANDO CONSULTAS PRESENCIAIS NO NOSSO NOVO LOCAL EM ORLANDO, FL. LIGUE JÁ (978) 453-7225 MARQUE JÁ ORLANDO Estamos atendendo MT6:33b DANILO BRACK ADVOGADO BRASILEIRO NOS EUA MASSACHUSETTS FLORIDA RIO DE JANEIRO RIO GRANDE DO SUL IMIGRAÇÃO BUSQUE OS SEUS DIREITOS Para mais informações (978) 453-7225 WWW.BRACKLAW.COM.BR
MASSACHUSETTS







Georgeana Frias, eleita personalidade do ano em 2022, inaugura nova clínica de estética




Georgeana Frias é uma carioca que está se destacando nos Estados Unidos no ramo da estética e beleza, dona da clínica “Rio Medical”, seu business está fazendo tanto sucesso que ela vai inaugurar uma outra unidade no mês de julho de 2023, em Southboro, MA. No ano passado, Georgeana foi eleita personalidade do ano da comunidade brasileira pelos participantes do jantar de gala promovido pelo jornal Brazilian Times.



 Texto de Eliana Marcolino
Texto de Eliana Marcolino
16 da Redação da BT Magazine EMPREENDEDORISMO
978-562-0900 978-333-0931 265 Washington St Hudson, MA @riomedical
Natural do Rio de Janeiro, chegou aos Estados Unidos em 1989, formou-se em enfermagem e exerceu essa profissão por muitos anos. Trabalhou em asilo, hospital, e em clínicas de saúde (urgent care). Mãe de três filhos. Em 2007, quando seus filhos estavam todos na escola em tempo integral, decidiu voltar a estudar e completar o mestrado: “Me formei em 2010 como enfermeira de prática avançada, com essa formação, eu me dediquei exclusivamente na área estética, abri a clínica Rio Medical em 2013. Tenho 10 anos de experiência atuando na área de estética médica”.
Georgeana especializou-se em estética e cuidados com a saúde e beleza. A novidade da sua clínica “Rio Medical” é que estão oferecendo tratamentos para emagrecimento, anti-envelhecimento e reposição hormonal, tanto para mulheres quan- to para


homens. Os clientes são bem variados, tem uma boa clientela de americanos, russos, libaneses, hispanos e brasileiros. Em sua equipe, a maioria fala português, além do inglês e espanhol.
Perguntamos
Georgeana sobre qual seria o diferencial do seu trabalho e ela nos responde com muita convicção: “Meu diferencial é o atendimento, foco muito na consulta e na avaliação da pessoa, percebo o que o cliente verdadeiramente precisa, analiso qual seria o tratamento mais adequado para ela, faço um tratamento individualizado. Jamais forço a pessoa a adquirir um serviço de que ela não precisa, os clientes se sentem confortáveis em minha clínica devido minha responsabilidade ética”.
A Rio Medical é uma clínica equipada com equipamentos de alta tecnologia, aprovada para uso nos Es-
tados Unidos, onde são ofertados serviços de injetáveis, contorno corporal, depilação à laser, cuidados com a pele, restauração capilar PRP, terapia hormonal Biote, rejuvenescimento vaginal. Além disso, a clínica é apoiadora da comunidade LGBTQI+: “Somos orgulhosos apoiadores da comunidade LGBTQ e temos a confiança de nossos clientes para fornecer uma variedade de tratamentos a partir de um local de inclusão, respeito e sensibilidade”. Declara em seu site.


Para Georgeana a chave do sucesso “é o amor à profissão”. Sente-se honrada com a confiança que as pessoas depositam em seu trabalho, está sempre estudando e evoluindo para oferecer o que há de melhor e mais moderno aos seus clientes que buscam saúde, bem-estar e beleza.
Em suas palavras finais, Georgeana faz uma homenagem à sua querida mãe, Elza Marcelino, que é sua grande incentivadora e motivo de orgulho, respeito e admiração.
da Redação da BT Magazine GEORGEANA FRIAS
Georgeana e sua mãe Elza Marcelino
própria, chamada Grafibrindes. No começo, ele e sua esposa, Luciana, não tinham equipamentos, vendiam os serviços e terceirizavam a produção. Com o tempo foram crescendo e aumentando a empresa e logo precisaram mudar para um espaço maior, com mais produtos à disposição e mais equipamentos.



ASpeedmax Signs é uma empresa de comunicação visual fundada por um casal brasileiro, Leandro do Vale e Luciana Silva, apaixonado por design, com o objetivo de trazer um diferencial criativo para o mercado de comunicação visual nos Estados Unidos. A missão principal é proporcionar soluções inovadoras e personalizadas que transformam ideias em realidade, cativando o público e destacando a identidade única de cada cliente.
Por que escolher a Speedmax Signs?









Uma das principais qualidades é que a empresa combina o conhecimento adquirido em uma carreira internacional com a paixão inegável pela criatividade e cores vibrantes que caracterizam o Brasil. Isso lhe permite
oferecer perspectivas únicas e resultados impactantes para seus clientes.
Além disso, os proprietários da empresa sabem como é importante se sentir compreendido e expressar suas ideias de forma clara. “Com nossa equipe fluente em português e inglês, garantimos uma comunicação fluida e eficiente durante todo o processo de criação a instalação”, afirmam.


Outra qualidade da SpeedMax Signs é a transformação que a identidade visual causa nos negócios, modernidade e conexão do público. “Temos diversos casos de empresas que tiveram seus negócios transformados para sua melhor versão através de nosso trabalho, criando um ambiente onde sua marca é valorizada”.
“Entendemos que cada projeto é único, por isso nossas soluções são totalmente personalizadas para atender às suas necessidades específicas. Desde banners e outdoors até design de interiores e logotipos, estamos preparados para dar uma cara mais profissional, cativante e consistente para sua empresa”, afirmou.
TROFÉU NOTÁVEIS USA
A qualidade do trabalho da empresa chamou a atenção da organização do Notable Brazilian Award, o evento conhecido como Notáveis USA. Em 2022, o casal compareceu ao evento, em New York, por ocasião de Luciana Silva ter sido indicada e recebeu a homenagem.

Na época, Luciana e Leandro perceberam um grande potencial em melhorar a produção do material do prêmio dado aos homenageados. “Fiz o primeiro contato com a produção durante o evento e como um bom vendedor estamos sempre atentos a oportunidades”, disse ele. “Após primeiro contato me propus a fazer um modelo mais bonito e elegante e a ideia foi aceita”, fala festejando que hoje os troféus que serão entregues no Notáveis USA neste ano foram produzidos por sua empresa. “É um troféu todo produzido em acrílico com gravação a laser”, explicou.
SERVIÇOS
Design Gráfico, Sinalização Personalizada, Comunicação Visual em Eventos,


A HISTÓRIA
Leandro é natural de Brasília (DF) e trabalho no ramo gráfico e comunicação visual há 20 anos. Ele começou a trabalhar na área serigrafia ano de 2000, como ajudante de produção, e com o tempo adquiriu uma vasta experiência. Ele passou por vários setores na empresa e em 2006 abriu a sua
Em 2018, o casal se mudou para os Estados Unidos e fixou residência na cidade de Orlando, Flórida, e não demorou muito para abrir uma empresa que leva a experiência dos dois em todos os seus produtos, a Speedmax Signs. “Apesar de já termos uma grande experiência no Brasil, tivemos que começar do zero, mas com muito trabalho e dedicação fomos crescendo e hoje temos um lugar de destaque”, disse Leandro.


dência na cidade de Orlando, abrir uma empresa que leva a experitodos dutos, a Speedmax Signs. “Apesar de Brasil, tivemos que começar do zero, oferecer







Ele lembra que no início a empresa foi montada em um espaço de 60 metros quadrados e apenas uma máquina de impressão. Os primeiros dois anos foram bastante difíceis, pois com inglês bem limitado e falta de conhecimento do mercado tiveram que lutar muito para conquistar os clientes. “Nós mostrávamos nossos produtos em eventos, festas e reuniões de empresários e assim todos foram nos conhecendo e nós ficamos conhecendo o mercado”, explicou.
Leandro disse que a diferença dos dois mercados é que no Brasil o principal produto eram brindes promocionais e “aqui esse produto não traz muitos resultados”. “Foi assim que começamos a estudar e entender o mercado”, explicou.

Dois anos após a abertura da empresa, o casal saiu de um escritório de 60 metros quadrados para uma loja de 170 metros quadrados. Eles adquiriram novos equipamentos e hoje a Speedmax signs conta com uma estrutura de 8 máquinas de impressão e corte de grandes formatos para diversos tipos de materiais, 6 colaboradores, uma área de atendimento, criação de arte, produção, instalação e duas vans.
CONTATO




























A Speedmax Signs está localizada no 6801 S Orange Avenue, em Orlando (Flórida). O horário de funcionamento é: Segunda a sexta - 9am - 6pm. A empresa envia para todo os Estados Unidos
Para mais informações ou fazer um orçamento ligue no telefone 1 407704-7696 ou acesse nosso instagram: @speedmaxsign
18 da Redação da BT Magazine EMPRESA DESTAQUE
Empresa é a responsável pela produção dos troféus do NOTÁVEIS USA
a sua parceira em propaganda visual nos Estados Unidos
própria, chamada Grafibrindes.
único, por isso nossas soluções são












Dra Bernadete Campos a saúde bucal está para além de um sorriso
ADoutora Bernadete Campos veio de Coroaci, cidadezinha do interior de Minas Gerais. Ela se formou em Odontologia pela Universidade Vale do Rio Doce –Univale, em Governador Valadares. Logo especializou-se em periodontia e implantes, na Universidade Federal dos Vales do Jequitinhonha e Mucuri (UFVJM), campus de Diamantina.



e preenchimentos faciais. É uma clínica com uma ampla cartela de serviços. A Dra. Bernadete fala das facilidades que o seu consultório oferece aos clientes: “Nós oferecemos um membership do consultório, a fim de ajudar os pacientes com menor poder aquisitivo. Também atendemos vários seguros dentários, como Delta Dental, Blue Cross Blue Shield, Metlife, Aetna and Colonial. Também aceitamos Masshealth para crianças e consultas de emergência para adultos”.
e assim me tornei uma dentista com visão di-















A Dra. Bernadete nos conta o motivo que a levou escolher esta profissão: “Eu escolhi minha profissão porque morria de medo de dentista! Quando criança, eu sempre chorava durante meu tratamento odontológico. Então pensei: Isso pode e precisa ser ressignificado! Vou fazer da minha insegurança o pontapé para a escolha do meu caminho profissional, e assim me tornei uma dentista com visão diferenciada”.

Em 2008 Dra. Bernadete mudou-se para os Estados Unidos, com o filho de 10 anos, em busca de uma vida com melhores pos- sibilidades. Ela nos contou que não sabia sequer uma única palavra em inglês, mas como é apaixonada pela profissão, esforçou-se e se dedicou ao máximo para aprender aquele idioma e assim renovar sua licença profissional aqui nos EUA. Em 2015 formou-se novamente na Universidade de Boston (BU).
A Doutora Bernadete fala a respeito de uma das maiores reclamações dos brasileiros que é referente ao valor dos serviços odontológicos nos Estados Unidos: “Eu entendo que a população brasileira reclama dos custos dos tratamentos odontológicos daqui, mas é importante compreender que a formação profissional oferecida nos EUA é muito cara. Um bom profissional da odontologia precisa investir muito na sua carreira, quer seja por meio de educação continuada, em cursos de atualização, na aquisição de materiais e equipamentos de alta qualidade e tecnologia, bem como em funcionários capacitados”.
e assim renovar sua licença profis-

























“Estou sempre me atualizando e aprendenserviços de alta qualidade e com o máximo




“Estou sempre me atualizando e aprendendo técnicas novas de odontologia para prestar serviços de alta qualidade e com o máximo conforto para meus pacientes. Be Fresh Dental foi criado em 2021. “Be”, porque é meu apelido e “Fresh” por estamos perto do Fresh Pond em Cambridge, bem como porque estamos construindo um método inovador, confortável e descontraído, por meio do uso de alta tecnologia”






O diferencial do trabalho da Doutora Bernadete é que ela conta com uma equipe de profissionais altamente qualificados para atender a comunidade brasileira. Todos os funcionários falam português, oferecem um ambiente familiar com atendimento personalizado e horários especiais (noites e sábados), para melhor atender a população que trabalha. Além disso, a equipe está preparada para atender os pacientes de maneira humanizada, com muito carinho e respeito.

atender a população que trabalha. Além disa
“A chave do sucesso para mim é primeiro amar o que se faz. Em seguida, estabelecer disciplina, dedicação e perseverança, sem que esqueçamos do mais importante; o cultivo da fé e a gratidão em todos os momentos”.
em porcelana e resina, tratamento de gengiva


relho ortodôntico ( Invisalign), botox







































































A Dra. Bernadete tem mais de 20 anos de experiência profissional e hoje o seu consultório conta com uma excelente equipe de profissionais. Eles oferecem todos os tipos de procedimentos odontológicos, tais como Planejamento Digital do sorriso, lentes de contato em porcelana e resina, tratamento de gengiva cirúrgico e não cirúrgico, implantes dentários, tratamento de canal, aparelho ortodôntico ( Invisalign), botox

20
20

Texto de Eliana Marcolino
Texto de Eliana Marcolino































































































































